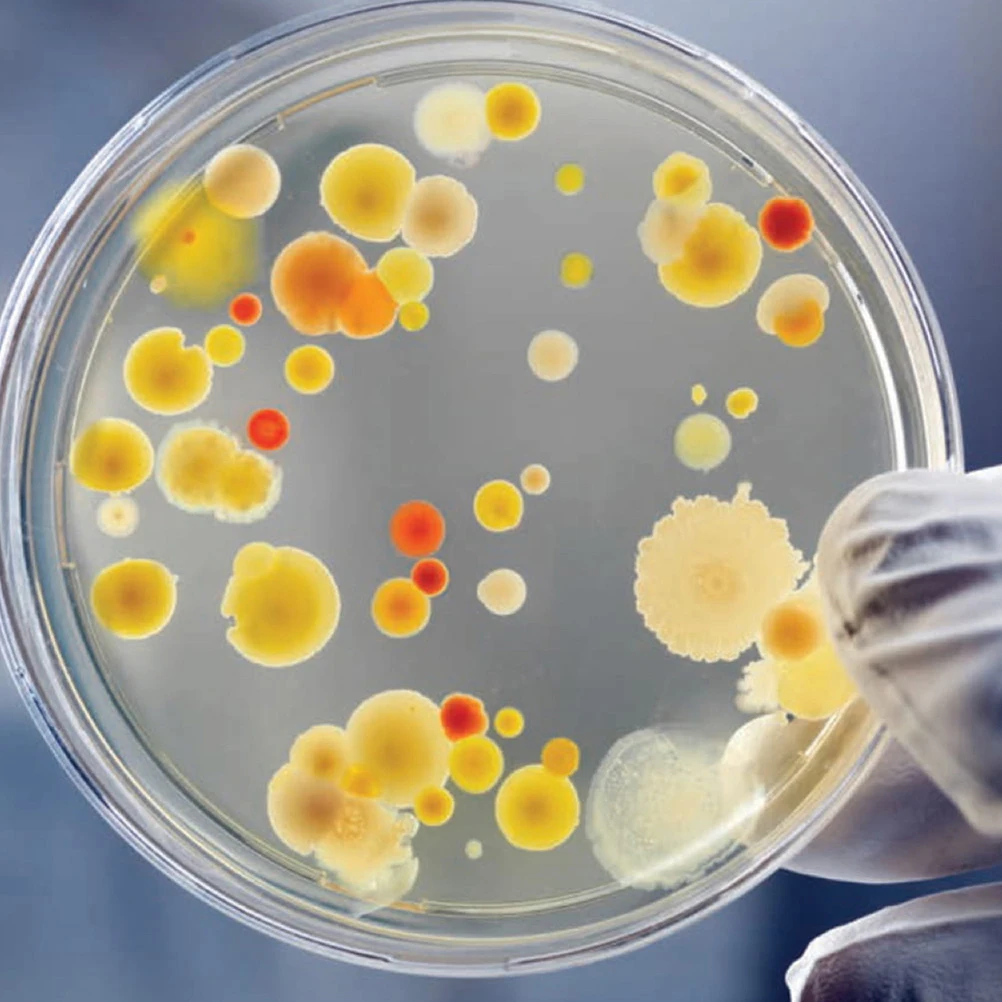
30pcs Dish Culture Dishes 90mm Disposable Transparent Plastic Lids for Lab Experiment Biology Transparent Petri Dishes Study

Спортивное трикотажное платье выше колена, короткое с длинными рукавами и цветочным принтом. Серое

Seventeen
sku: 1179205243
ACCORDING TO OUR RECORDS THIS PRODUCT IS NOT AVAILABLE NOW
528.00 грн.
Shipping from: Ukraine
Description
Оригинальное платье-свитшот в нестандартном и ультрасовременном покрое подола - чуть укороченное впереди и удлиненное сзади. Такое решение сделает ваши ножки визуально еще красивее. Подойдет как самостоятельный образ, так и в ансамбле с лосинами или джинсами. Невероятно нежное платье-свитшот серого цвета с красивым цветочным принтом можно купить быстро и недорого. В интернет-магазине «Seventeen» эксклюзивные новинки от производителя можно заказать в розницу по выгодной стоимости или оптом по цене со скидкой. Любой из вариантов сэкономит вам деньги и обеспечит хорошее настроение на весь день! Серое платье оригинального фасона порадует вас своим отменным качеством и универсальностью в сочетании с другими предметами гардероба. Материал: двунитка,принтованная двунитка.
Длина изделия по спине: M =90см., L = 91см; XL= 92см, XXL= 93 см; Длина рукава : M =62см., L = 62,5 см; XL= 63 см; XXL= 63,5 см. Цвет: серый/принтВнимание! Актуальное наличие размеров смотрите ниже в "Дополнительные(пользовательские) характеристики" в разделе "Размер":
Длина изделия по спине: M =90см., L = 91см; XL= 92см, XXL= 93 см; Длина рукава : M =62см., L = 62,5 см; XL= 63 см; XXL= 63,5 см. Цвет: серый/принтВнимание! Актуальное наличие размеров смотрите ниже в "Дополнительные(пользовательские) характеристики" в разделе "Размер":
Price history chart & currency exchange rate
Customers also viewed

1,146.07 грн.
Для BMW Z4 E85 E86 2002-2008 Автомобильная Передняя панель держатель стакана для воды доска для приборной панели с вентиляционным отверстием
aliexpress.ru
1,160.76 грн.
Для BMW 3 серии E46 316i 318i 320i 325i 328i 330i 2002-2004, автомобильная фара головного света, искусственная стеклянная линза, чехол
aliexpress.ru
4,211.36 грн.
Kisswhite Новая длинная фата, двухслойная, блестящая, блестящая, с кристаллами, фата 3x3,5 метра
aliexpress.ru
1,368.41 грн.
Купальник женский разных цветов, пикантная короткая юбка в европейском и американском стиле, купальник-бикини с лямкой на шее и разрезом
aliexpress.ru
362.03 грн.
Мужская модная рубашка с длинными рукавами для вечеринки 2024, рубашка с 3D принтом льва, с высоким разрешением, с лацканами и животным принтом, мужские топы
aliexpress.ru
285.26 грн.
1:12 миниатюрный деревянный кукольный домик, двухуровневый стол для хранения, мебель, модель, Декор, игрушка, кукольный домик, аксессуары, украшение
aliexpress.ru
378.39 грн.
Принадлежности для чистки труб, товары для рукоделия, творческое украшение для цветов, материал для тюльпанов ручной работы, упаковка для праздничного украшения
aliexpress.ru
219.82 грн.
Полировочный спрей для мебели, 120 мл, универсальный пчелиный воск, аналогичный воску, приправа, деревянный износостойкий резистор
aliexpress.ru
269.32 грн.
Силиконовый захват в виде кольца, устройство для снятия стресса, устройство для тренировки мышц, тренажерного зала, фитнеса
aliexpress.ru
3,926.10 грн.
500PCS NEW 1.2ml Gold Pretty Empty Clear Lip Gloss Tube Lip Balm bottle Container 1.2 ML PET 11mm*43mm 500PCS/LOT MINI *FD118
aliexpress.com
2,191.96 грн.
Координатное худи на молнии с логотипом цвета ледяного мергеля ASOS Weekend Collective
cdek.shopping
10,157.48 грн.
Xiaomi Redmi Note 12 | 8GB RAM | 256GB Storage | Smooth 120Hz AMOLED display | Powerful Snapdragon® processor | 50MP AI triple camera | 33W fast c...
erosdigitalhome.ae
51.60 грн.
Aquarium Manual Clean Pipette 50Ml Fish Tank Cleaner Transparent Durable Aquarium Cleaning Tool Fish Tank Water Changer Pink
aliexpress.com
28,292.76 грн.
European Style Aluminum Entrance Pivot Door Double Open Metal Frame Anti-theft Doors Aluminium French Colorful Front Entry Door
aliexpress.com
46.98 грн.
Tire Liner Scraper Tire Inside Scraper Tire Inner Liner Scraper Hoe Liner Scraper Grade Radial Repair Patch Tool
aliexpress.com
179.13 грн.
Gojo Satoru And Geto Suguru Phone Case For Iphone 15 11 13 14 Pro Max 7 8 Plus X Xr Xs Max Se2020 12mini Cover Case
aliexpress.com
101.10 грн.
Blood Bags for Drinks Beverage Halloween Party Container Pouches Transparent Props
aliexpress.com
130.05 грн.
30pcs Dish Culture Dishes 90mm Disposable Transparent Plastic Lids for Lab Experiment Biology Transparent Petri Dishes Study
aliexpress.com
1,643.60 грн.
Color Temperature Tester High Precise Illuminance Meter 0.5-300000LUX LED Illumination Test Meter Luminance Measuring
aliexpress.com
729.51 грн.
Women's Long Sleeve PU Leather Coat, Windbreaker, British Fashion Top, Fashionable long women's clothing
aliexpress.com













